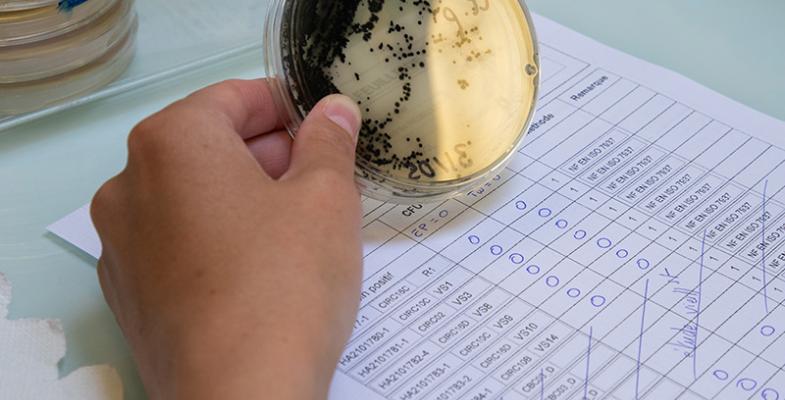

En octobre dernier, le laboratoire départemental d'analyse LDA33 a été audité par le COFRAC (Comité Français d'Accréditation)*, l'unique organisme d'accréditations en France. Cet audit, renouvelé tous les 15 mois, a pour but l'obtention et le maintien des agréments ministériels, gage de qualité pour le laboratoire.
Un audit : pourquoi ?
L'audit est une démarche obligatoire pour le LDA33, qui conditionne le maintien des accréditations et des agréments. Ces derniers permettent au laboratoire de réaliser des prélèvements et des analyses dans le cadre des contrôles officiels et des autocontrôles.
Les accréditations sont délivrées par le COFRAC, après l'évaluation d'exigences, à la fois normatives et réglementaires. L'objectif étant d'attester la qualité des analyses, leur fiabilité, les compétences des équipes et leur l'impartialité.
En ce sens, le LDA33 s'engage auprès de ses clients à toujours augmenter la qualité de ses pratiques tout en garantissant le respect des normes.
En 2020, l'expérience est à nouveau réussie, réitérant ainsi la confiance à notre laboratoire.
*Accréditations Cofrac Essais, n°1-1955 et 1-1466, liste des sites et portée disponibles sous www.cofrac.fr